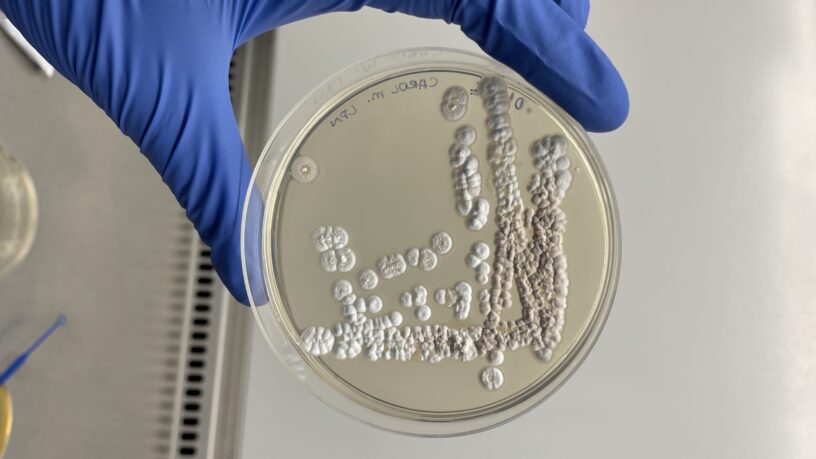
noticias_generica_lnbio-premio-genetica-2023-scaled

Sociedade Brasileira de Genética premia pesquisa com bactérias de solo amazônico
Parceria entre CNPEM, UFPA e Biotec-Amazônia busca moléculas de interesse farmacêutico em microrganismos da Amazônia Ana Carolina de Oliveira, aluna de doutorado responsável pelo estudo O pôster sobre pesquisa que isolou bactérias de solo da região amazônica e explorou a possibilidade de produção de novos fármacos a partir das moléculas sintetizadas por essas bactérias levou…